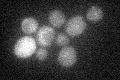
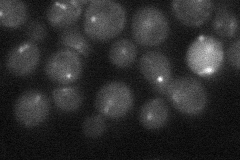
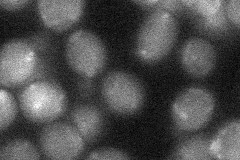
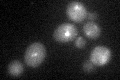

View description
Essential kinetochore protein associated with microtubules and spindle pole bodies; component of the kinetochore sub-complex COMA (Ctf19p, Okp1p, Mcm21p, Ame1p); involved in spindle checkpoint maintenance
Localization:
Intensity:
Fold change:
Significance:
-
C’ GFP library in SD
below threshold17.44 -
N' NOP1pr-GFP in SD

punctate30.9245 -
N' TEF2pr-mCherry in SD

punctate15.1154 -
N' NATIVEpr-GFP in SD
punctate23.8649 -
N' TEF2pr-VC and Cyto-VN in SD
below threshold26.9917 -
C’ GFP library in SD+DTT
cytosol16.250.93No -
C’ GFP library in SD+H2O2

cytosol16.960.97No -
C’ GFP library in Starvation Media

cytosol15.670.89No -
C’ GFP library on the background of Pup2-DaMP

below threshold -
C’ GFP library on the background of CCT mutant

below threshold18.69681.07132No
